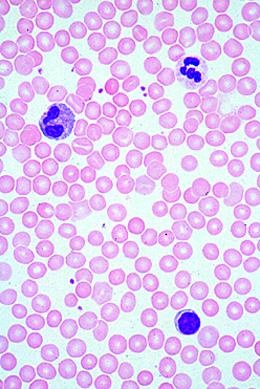
Allgemeinwissen Mikroskopie, Basissatz von 6 Einheiten, Lehrerpaket

Mikropräparate Multimediapakete – Digitale Lernpakete für Mikroskopie
Mikropräparate Multimediapakete kombinieren klassische Dauerpräparate mit digitalen Lerninhalten für einen modernen und anschaulichen Biologieunterricht.
Die Pakete ermöglichen eine effektive Verbindung von Mikroskopie und multimedialem Lernen, ideal zur Vermittlung komplexer biologischer Strukturen und Prozesse.
Perfekt geeignet für Schule, Ausbildung und Studium.
Weitere Kategorien
Die Multimediapakete enthalten ergänzende Materialien wie interaktive Inhalte, Begleittexte und didaktische Aufbereitungen, die speziell auf den Einsatz im Unterricht abgestimmt sind.
Sie unterstützen Lehrkräfte und Lernende im deutschsprachigen Raum und entsprechen aktuellen Lehrplänen in Deutschland, Österreich und der Schweiz.
Entdecken Sie auch unsere klassischen Mikropräparate sowie thematische Serien für Zoologie und Botanik.